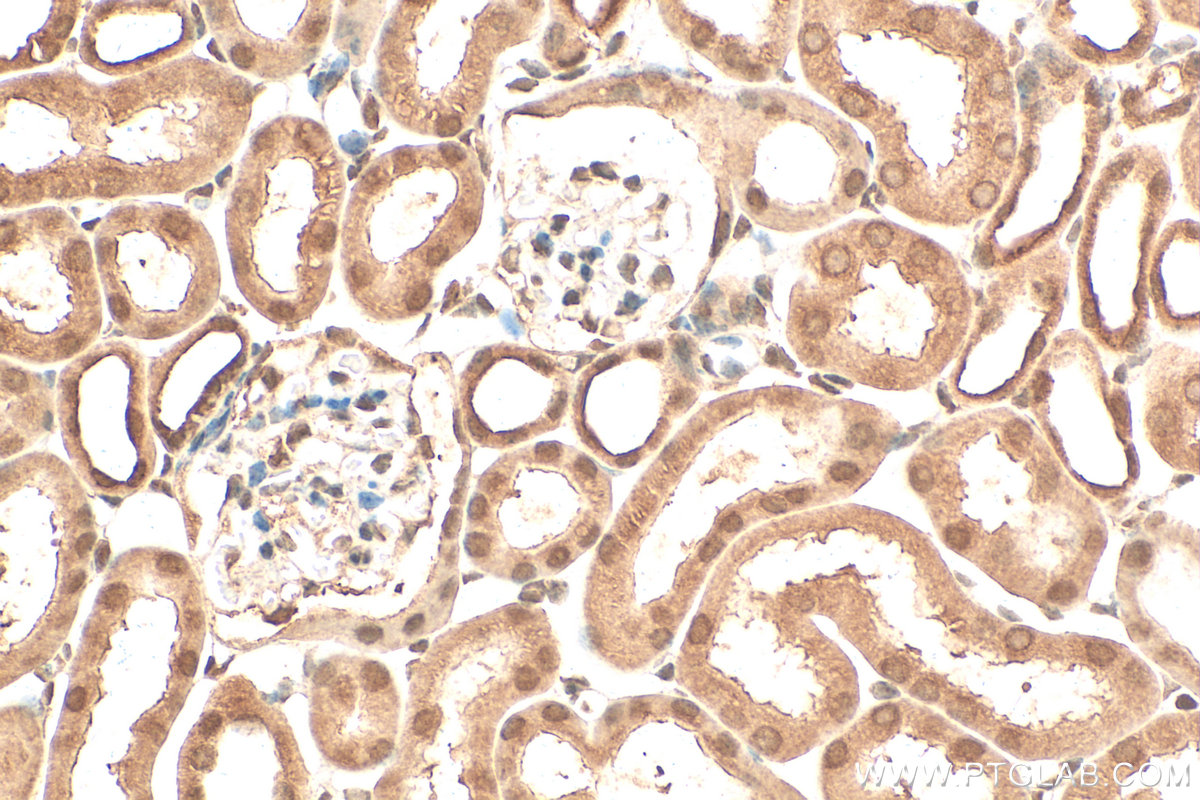

验证数据展示
经过测试的应用
| Positive WB detected in | HEK-293 cells, HeLa cells, mouse testis tissue, HepG2 cells, Jurkat cells, K-562 cells |
| Positive IP detected in | HEK-293 cells |
| Positive IHC detected in | human kidney tissue, human brain tissue, human heart tissue, human lung tissue, human ovary tissue, human placenta tissue, human skin tissue, human spleen tissue, human testis tissue, mouse brain tissue, mouse kidney tissue, mouse liver tissue Note: suggested antigen retrieval with TE buffer pH 9.0; (*) Alternatively, antigen retrieval may be performed with citrate buffer pH 6.0 |
| Positive IF/ICC detected in | HepG2 cells |
推荐稀释比
| 应用 | 推荐稀释比 |
|---|---|
| Western Blot (WB) | WB : 1:2000-1:16000 |
| Immunoprecipitation (IP) | IP : 0.5-4.0 ug for 1.0-3.0 mg of total protein lysate |
| Immunohistochemistry (IHC) | IHC : 1:50-1:200 |
| Immunofluorescence (IF)/ICC | IF/ICC : 1:750-1:3000 |
| It is recommended that this reagent should be titrated in each testing system to obtain optimal results. | |
| Sample-dependent, Check data in validation data gallery. | |
产品信息
11708-1-AP targets SMN in WB, IHC, IF/ICC, IP, ELISA applications and shows reactivity with human, mouse, rat samples.
| 经测试应用 | WB, IHC, IF/ICC, IP, ELISA Application Description |
| 文献引用应用 | WB, IF, IP, ELISA |
| 经测试反应性 | human, mouse, rat |
| 文献引用反应性 | human, mouse, rat |
| 免疫原 |
CatNo: Ag2260 Product name: Recombinant human SMN2 protein Source: e coli.-derived, PGEX-4T Tag: GST Domain: 1-282 aa of BC000908 Sequence: MAMSSGGSGGGVPEQEDSVLFRRGTGQSDDSDIWDDTALIKAYDKAVASFKHALKNGDICETSGKPKTTPKRKPAKKNKSQKKNTAASLQQWKVGDKCSAIWSEDGCIYPATIASIDFKRETCVVVYTGYGNREEQNLSDLLSPICEVANNIEQNAQENENESQVSTDESENSRSPGNKSDNIKPKSAPWNSFLPPPPPMPGPRLGPGKPGLKFNGPPPPPPPPPPHLLSCWLPPFPSGPPIIPPPPPICPDSLDDADALGSMLISWYMSGYHTGYYMEMLA 种属同源性预测 |
| 宿主/亚型 | Rabbit / IgG |
| 抗体类别 | Polyclonal |
| 产品类型 | Antibody |
| 全称 | survival of motor neuron 2, centromeric |
| 别名 | C BCD541, Component of gems 1, Gemin 1, Gemin-1, SMN1 |
| 计算分子量 | 282 aa, 30 kDa |
| 观测分子量 | 38 kDa |
| GenBank蛋白编号 | BC000908 |
| 基因名称 | SMN |
| Gene ID (NCBI) | 6607 |
| RRID | AB_2255114 |
| 偶联类型 | Unconjugated |
| 形式 | Liquid |
| 纯化方式 | Antigen affinity purification |
| UNIPROT ID | Q16637 |
| 储存缓冲液 | PBS with 0.02% sodium azide and 50% glycerol, pH 7.3. |
| 储存条件 | Store at -20°C. Stable for one year after shipment. Aliquoting is unnecessary for -20oC storage. |
背景介绍
Spinal muscular atrophy (SMA) is an autosomal recessive neurodegenerative disease characterized by loss of anterior horn cells in the spinal cord and concomitant symmetrical muscle weakness and atrophy (PMID: 16364894 ). SMA is caused by deletion or mutations of the survival motor neuron (SMN1) gene. SMA patients lack a functional SMN1 gene, but they possess an intact SMN2 gene, which though nearly identical to SMN1, is only partially functional (PMID: 17355180). A large majority of SMN2 transcripts lack exon 7, resulting in production of a truncated, less stable SMN protein (PMID: 10369862). The level of SMN protein correlates with phenotypic severity of SMA. This antibody, 11708-1-AP, raised against the recombinant full-length human SMN2 protein, recognizes all isoforms of SMN protein.
实验方案
| Product Specific Protocols | |
|---|---|
| IF protocol for SMN antibody 11708-1-AP | Download protocol |
| IHC protocol for SMN antibody 11708-1-AP | Download protocol |
| IP protocol for SMN antibody 11708-1-AP | Download protocol |
| WB protocol for SMN antibody 11708-1-AP | Download protocol |
| Standard Protocols | |
|---|---|
| Click here to view our Standard Protocols |
发表文章
| Species | Application | Title |
|---|---|---|
Nat Commun SNUPN deficiency causes a recessive muscular dystrophy due to RNA mis-splicing and ECM dysregulation | ||
Dev Cell DDX20 is required for cell-cycle reentry of prospermatogonia and establishment of spermatogonial stem cell pool during testicular development in mice | ||
Hum Mol Genet SMN expression is required in motor neurons to rescue electrophysiological deficits in the SMNΔ7 mouse model of SMA. | ||
Hum Mol Genet Low levels of Survival Motor Neuron protein are sufficient for normal muscle function in the SMNΔ7 mouse model of SMA. | ||
Neurobiol Dis Dual SMN inducing therapies can rescue survival and motor unit function in symptomatic ∆7SMA mice. | ||
Hum Mol Genet Intragenic complementation of amino and carboxy terminal SMN missense mutations can rescue Smn null mice.
|